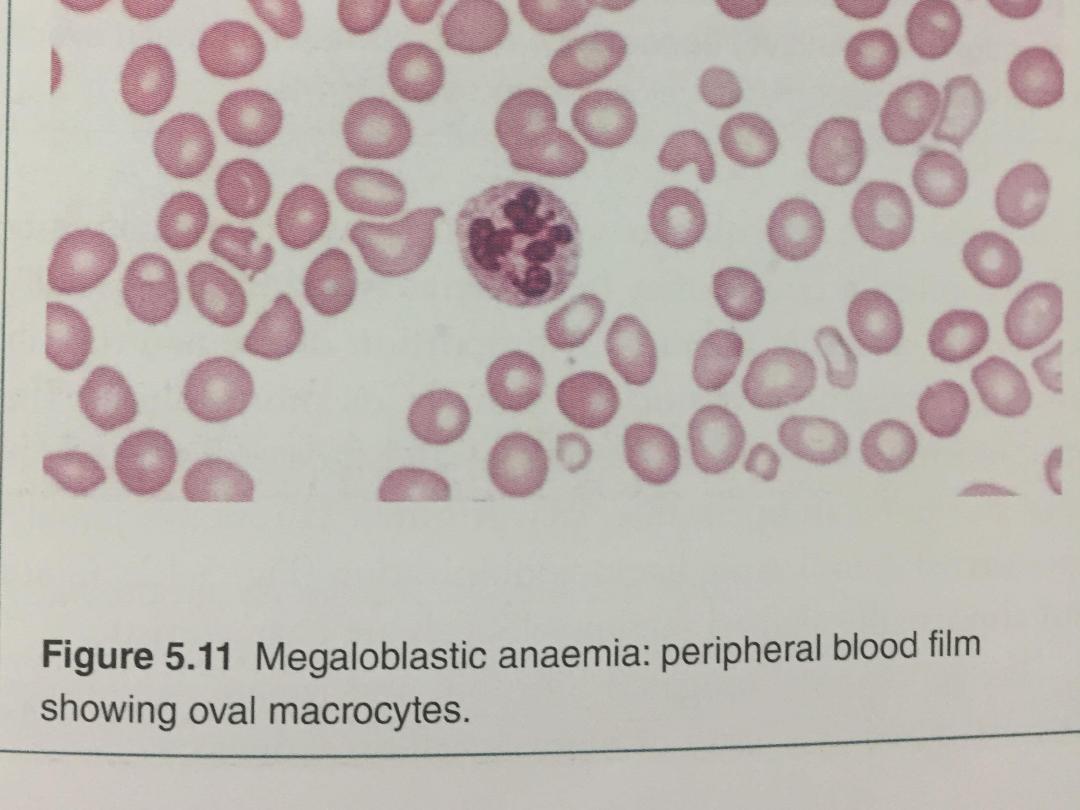

Megaloblastic anaemia
•This results from a deficiency of vitamin B12 or
folic acid, or from disturbances in folic acid
metabolism. vitamin B12 a co-factor for, the
generation of the essential amino acid
methionine from homocysteine.
•The megaloblastic changes are most evident in
the early nucleated red cell precursors, and
haemolysis within the marrow results in a raised
bilirubin and lactate dehydrogenase (LDH), but
without the reticulocytosis characteristic of other
forms of haemolysis

• Iron stores are usually raised. The mature red cells are
large and oval, and sometimes contain nuclear remnants.
The mature neutrophils show hypersegmentation of their
nuclei, with cells having six or more nuclear lobes. If
severe, a pancytopenia may be present in the peripheral
blood.
• Vitamin B12 deficiency, but not folate deficiency, is
associated with neurological disease in up to 40% of
cases, although advanced neurological disease due to B12
deficiency is now uncommon in the developed world.
• The main pathological finding is focal demyelination
affecting the spinal cord, peripheral nerves, optic nerves
and cerebrum.
The most common manifestations are sensory, with
peripheral paraesthesiae and ataxia of gait.

Vitamin B12
Vitamin B12 absorption
The average daily diet contains 5–30 μg of vitamin B12,
mainly in meat, fish, eggs and milk – well in excess of the
1 μg daily requirement.
In the stomach, gastric enzymes release vitamin B12
from food and at gastric pH it binds to a carrier protein
termed R protein.
Gastric parietal cells produce intrinsic factor, a vitamin
B12- binding protein which optimally binds vitamin B12
at pH 8.
As gastric emptying occurs, pancreatic secretion raises
the pH and vitamin B12 released from the diet switches
from the R protein to intrinsic factor.
Bile also contains vitamin B12 which is available for
reabsorption in the intestine.

• The vitamin B12–intrinsic factor complex binds to
specific receptors in the terminal ileum, and vitamin
B12 is actively transported by the enterocytes to
plasma, where it binds to transcobalamin II, a transport
protein produced by the liver, which carries it to the
tissues for utilisation.
• The liver stores enough vitamin B12 for 3 years and
this, together with the enterohepatic circulation, means
that vitamin B12 deficiency takes years to become
manifest, even if all dietary intake is stopped or severe
B12 malabsorption supervenes.
• Blood levels of vitamin B12 provide a reasonable
indication of tissue stores and are usually diagnostic of
deficiency.
•

Causes of vitamin B12 deficiency
•Dietary deficiency
This only occurs in strict vegans but the onset
of clinical features can occur at any age
between 10 and 80 years.
•Gastric pathology
Release of vitamin B12 from the food requires
normal gastric acid and enzyme secretion, and
this is impaired by hypochlorhydria in elderly
patients or following gastric surgery.
•

•Pernicious anaemia
This is an organ-specific autoimmune disorder
in which the gastric mucosa is atrophic, with
loss of parietal cells causing intrinsic factor
deficiency.
•It is more common in individuals with other
autoimmune disease (Hashimoto’s thyroiditis,
Graves’ disease, vitiligo, hypoparathyroidism or
Addison’s disease or a family history of these or
pernicious anaemia
•The finding of anti-intrinsic factor antibodies in
the context of B12 deficiency is diagnostic of
pernicious anaemia without further
investigations.

V1.0

V1.0

V1.0
Small bowel pathology

V1.0

V1.0
Folate
Folate absorption
Folates are produced by plants and bacteria;
hence dietary leafy vegetables (spinach,
broccoli, lettuce), fruits (bananas, melons)
and animal protein (liver, kidney) are a rich
source. Total body stores of folate are small
and deficiency can occur in a matter of
weeks.

Folate deficiency
• The edentulous elderly or psychiatric patient is
particularly susceptible to dietary deficiency and this is
exacerbated in the presence of gut disease or
malignancy.
• Pregnancy-induced folate deficiency is the most
common cause of megaloblastosis worldwide and is
more likely in the context of twin pregnancies,
multiparity and hyperemesis gravidarum.
• Serum folate is very sensitive to dietary intake; a
single folate-rich meal can normalise it in a patient with
true folate deficiency, whereas anorexia, alcohol and
anticonvulsant therapy can reduce it in the absence of
megaloblastosis.

•For this reason, red cell folate levels are a
more accurate indicator of folate stores and
tissue folate deficiency

V1.0

V1.0

V1.0

V1.0

V1.0
V1.0

Management of megaloblastic Anaemia
• If a patient with a severe megaloblastic anaemia is very
ill and treatment must be started before vitamin B12
and red cell folate results are available, that treatment
should always include both folic acid and vitamin B12.
• The use of folic acid alone in the presence of vitamin
B12 deficiency may result in worsening of neurological
deficits
• Vitamin B12 deficiency is treated with
hydroxycobalamin 1000 μg IM for 6 doses 2 or 3 days
apart, followed by maintenance therapy of 1000 μg
every 3 months for life. The reticulocyte count will peak
by the 5th–10th day after starting replacement therapy.

• The haemoglobin will rise by 10 g/L every week until
normalised. The response of the marrow is associated
with a fall in plasma potassium levels and rapid
depletion of iron stores.
• If an initial response is not maintained and the blood
film is dimorphic (i.e. shows a mixture of microcytic and
macrocytic cells), the patient may need additional iron
therapy.
• A sensory neuropathy may take 6–12 months to
correct; long-standing neurological damage may not
improve
• Folate deficiency :Oral folic acid 5 mg daily for 3 weeks
will treat acute deficiency and 5 mg once weekly is
adequate maintenance therapy.
•

• Prophylactic folic acid in pregnancy prevents megaloblastosis in
women at risk, and reduces the risk of fetal neural tube defects

V1.0

V1.0

Anaemia of chronic disease
• Anaemia of chronic disease (ACD) is a common type of
anaemia, particularly in hospital populations. It occurs
in the setting of chronic infection, chronic inflammation
or neoplasia.
• The anaemia is not related to bleeding, haemolysis or
marrow infiltration, is mild, with haemoglobin in the
range of 85–115 g/L,
• and is usually associated with a normal MCV
(normocytic, normochromic),though this may be
reduced in long-standing inflammation.
• The serum iron is low but iron stores are normal or
increased, as indicated by the ferritin or stainable
marrow iron

Pathogenesis
• It has recently become clear that the key regulatory
protein that accounts for the findings characteristic of
ACD is hepcidin, which is produced by the liver .
Hepcidin production is induced by proinflammatory
cytokines, and thereby inhibiting the export of iron
from these cells into the blood.
• The iron remains trapped inside the cells in the form of
ferritin,levels of which are therefore normal or high in
the face of significant anaemia. Inhibition or blockade of
hepcidin is a potential target for treatment of this form
of anaemia.

Diagnosis and management
•It is often difficult to distinguish ACD associated
with alow MCV from iron deficiency.
Examination of the marrow may ultimately be
required to assess iron stores directly.
•A trial of oral iron can be given in difficult
situations.
•A positive response occurs in true iron
deficiency but not in ACD.
•Measures which reduce the severity of the
underlying disorder generally help to improve
the ACD

V1.0

Primary idiopathic acquired aplastic
anaemia
•is failure of the pluripotent stem cells,
producing hypoplasia of the bone marrow with a
pancytopenia in the blood.
•The diagnosis rests on exclusion of other causes
of secondary aplastic anaemia and rare
congenital causes, such as Fanconi’s anaemia

Clinical features and investigations
•Patients present with symptoms of bone
marrow failure, usually anaemia or bleeding,
and less commonly, infections.
•An CBP demonstrates pancytopenia, low
reticulocytes and often macrocytosis.
•Bone marrow aspiration and trephine reveal
hypocellularity.

V1.0

V1.0

Management
• All patients will require blood product support and
aggressive management of infection. The prognosis of
severe aplastic anaemia managed with supportive
therapy only is poor and more than 50% of patients
die,usually in the first year.
• The curative treatment for patients under 30 years of
age with severe idiopathic aplastic anaemia is allogeneic
HSCT if there is an available donor
• Those with a compatible sibling donor should proceed to
transplantation as soon as possible; they have a 75–
90% chance of long-term cure.
• In older patients, immunosuppressive therapy with
ciclosporin and antithymocyte globulin gives 5-year
survival rates of 75%.

Secondary aplastic anaemia
•In some instances, the cytopenia is more
selective and affects only one cell line, most
often the neutrophils. Frequently, this is an
incidental finding, with no ill health. It probably
has an immune basis but this is difficult to
prove.
The clinical features and methods of diagnosis
are the Same